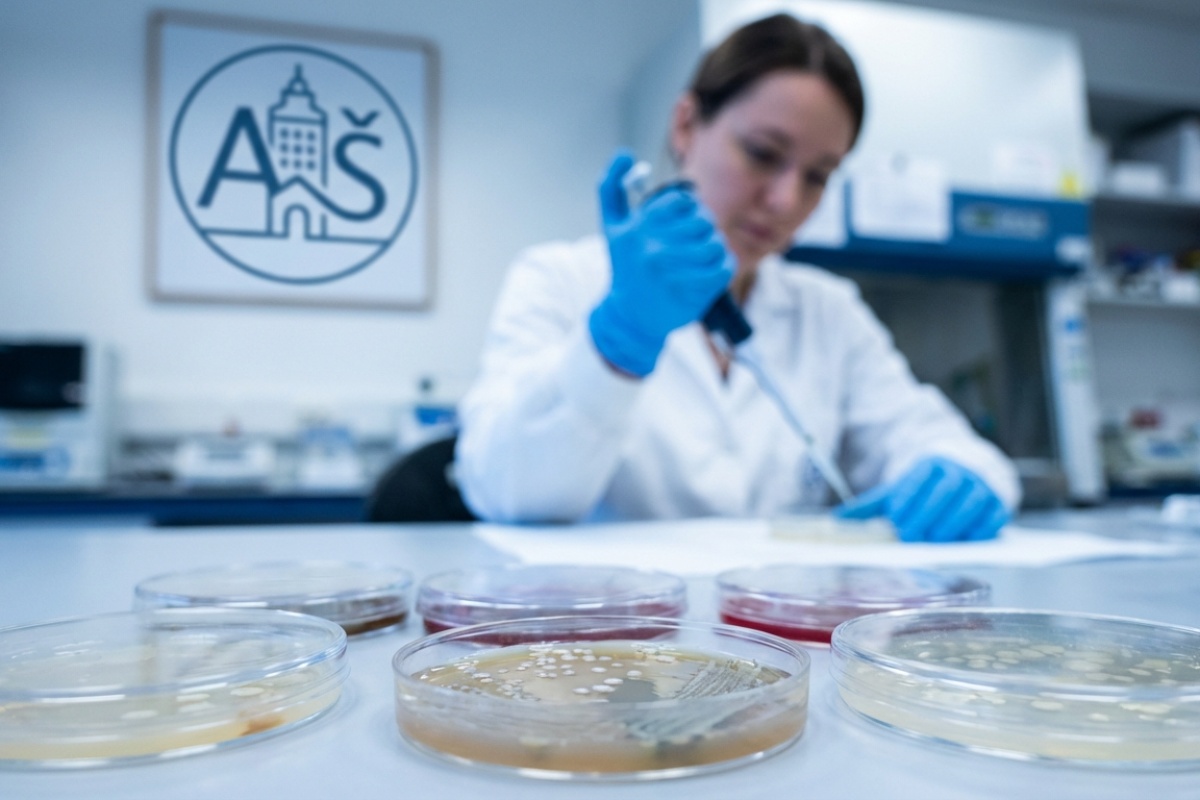
Zdravstvene vlasti potvrdile: u Zagrebu otkriven treći slučaj opasne bakterije detail 1

Širenje legionele u zagrebačkim ustanovama
Zagreb se suočava s novim izazovom u javnom zdravstvu nakon što je službeno potvrđena prisutnost bakterije legionele na trećoj lokaciji u gradu. Nakon dječjeg vrtića i sportskog objekta Mladost, opasna bakterija sada je izolirana i u sustavu vodoopskrbe jedne ustanove za starije osobe.
Uzorkovanje vode provedeno je u Domu za starije osobe Medveščak. Stručnjaci iz Nastavnog zavoda za javno zdravstvo „Dr. Andrija Štampar“ analizirali su ukupno 16 uzoraka vode, pri čemu je šest nalaza pokazalo pozitivne rezultate na prisutnost bakterije. Odmah po primitku nalaza, sanitarna inspekcija izdala je stroge telefonske upute za postupanje, kojima se zabranjuje korištenje vode na svim mjestima gdje je utvrđena kontaminacija.
Poduzete hitne sigurnosne mjere
U skladu s preporukama, u Domu Medveščak trenutno su na snazi zaštitne mjere kako bi se spriječilo eventualno obolijevanje korisnika. Ove mjere dio su standardnog protokola za suzbijanje legionarske bolesti, koja može biti posebno opasna za populaciju treće životne dobi i osobe narušenog imuniteta.
- Dječji vrtić: Sustav je trenutno u fazi sanacije i dezinfekcije.
- Mali bazen Mladost: Objekt je privremeno zatvoren za sve korisnike radi sigurnosti.
- Osnovna škola: Iako se rezultati analize još čekaju, mjere opreza su uvedene jer škola dijeli vodovodni sustav s vrtićem.

Iako su novi nalazi izazvali zabrinutost u javnosti, zdravstvene vlasti naglašavaju da trenutačno nema zabilježenih slučajeva oboljelih osoba. Sanacija i toplinska dezinfekcija sustava provode se prema najvišim standardima, a nadležne službe nastavljaju s pojačanim nadzorom gradskih vodovodnih instalacija.
